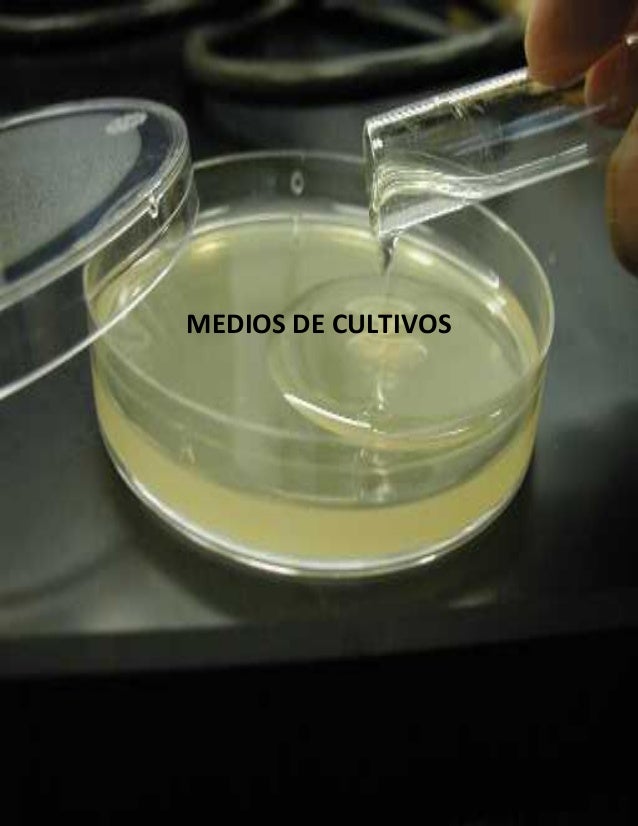
Medios de cultivo.

Un medio de cultivo es una técnica de laboratorio (véase microbiología) que consta de un gel o una solución que contiene los nutrientes necesarios para permitir, en condiciones favorables de pH y temperatura, el crecimiento de virus, microorganismos, células, tejidos vegetales o incluso pequeñas plantas. Según lo que se quiera hacer crecer, el medio requerirá unas u otras condiciones. Generalmente se presentan desecados en forma de polvo fino o granular antes de ser preparados; ya preparados pueden encontrarse en estado sólido, semisólido o líquido. El objetivo último del cultivo es variado: antibiograma, identificación, multiplicación.
Uno de los sistemas más importantes para la identificación de microorganismos es observar su crecimiento en sustancias alimenticias artificiales preparadas en el laboratorio. El material alimenticio en el que crecen los microorganismos es el Medio de Cultivo y el crecimiento de los microorganismos es el Cultivo. Se han preparado más de diez mil medios de cultivo diferentes.
Para que las bacterias crezcan adecuadamente en un medio de cultivo artificial debe reunir una serie de condiciones como: temperatura, grado de humedad y presión de oxígeno adecuadas, así como un grado correcto de acidez o alcalinidad. Existen rangos de temperatura dónde la tasa máxima de crecimiento se encuentra entre 20 y 42 °C. A esas bacterias se las conoce como mesófilas.[1] Un medio de cultivo debe contener los nutrientes mínimos para establecer un medio que contenga solamente los componentes necesarios para el crecimiento[2] y debe estar exento de todo microorganismo contaminante.
Los virus, por ejemplo, son obligados parásitos intracelulares, por lo que necesitan un medio que contenga células vivas.
Clasificación
Según sus cualidades físicas
- líquidos: Las bacterias aeróbicas de los cultivos con mayor profundidad crecen solamente en la superficie; mientras que las de menor profundidad se desarrollan por debajo de las condiciones y cada vez son más anaeróbicas.
- semisólidos[3]
- sólidos:[4] Para obtener un medio de cultivo sólido se introduce a los caldos de cultivos sustancias solidificantes, como por ejemplo agar agar, que dan a la disolución una consistencia gelatinosa.
Según su origen
- Naturales: son los preparados a partir de sustancias naturales de origen animal o vegetal como ser extractos de tejidos o infusiones y cuya composición química no se conoce exactamente.
- Sintéticos: son los medios que contienen una composición química definida cualitativamente y cuantitativamente. Se utilizan para obtener resultados reproducibles.
- Semisintéticos: son los sintéticos a los que se les añaden factores de crecimiento bajo una forma de un extracto orgánico complejo, como por ejemplo extracto de levadura.
Según su formulación
- Químicamente definidos: se conoce la cantidad exacta de cada uno de los compuestos que hay en el medio.
- Complejos: se realizan a partir de extractos naturales (extracto de levadura, sangre, etc.); no se conoce exactamente cuál es la composición del medio; sin embargo, presenta la ventaja de que ya están presentes todos o casi todos los elementos que una célula puede requerir. También para algunos grupos de organismos es común usar: mosto, leche de coco, jugo de zanahoria, etc. A este tipo de cultivo se lo denomina también no definido.[5]
Según su uso
- Medio general: medio en donde crecen todo tipo de microorganismos, excepto los que necesitan condiciones especiales (por ejemplo, agar CLED).
- Medio selectivo: permite seleccionar el crecimiento de una especie o grupo determinado (hongos, bacterias entéricas, protozoos...).
- Medio diferencial: permite identificar una especie con otra, ambas en el mismo medio. Puede ser por su crecimiento, su metabolismo,su respiración, etc. (por ejemplo, medio de McConkey).
- Medio de enriquecimiento: contiene los nutrientes necesarios para apoyar el crecimiento de una amplia variedad de microorganismos, se utiliza para la cosecha de diferentes tipos de microorganismos en un mismo medio.
- Medio mínimo: contiene la mínima cantidad de nutrientes posible que permite el crecimiento de una especie.
- Medio de transporte: preparado para servir como almacenamiento temporal a especímenes transportados o en transferencia; mantienen su viabilidad y su concentración simple.
Conteo bacteriano
Generalmente, tras analizar un cultivo, se realiza un conteo bacteriano, con el fin de saber cuál es la densidad de población microbiana que se encuentra en el medio.[6]
Véase también
- Medio de crecimiento para cultivo celular
Referencias

![]()